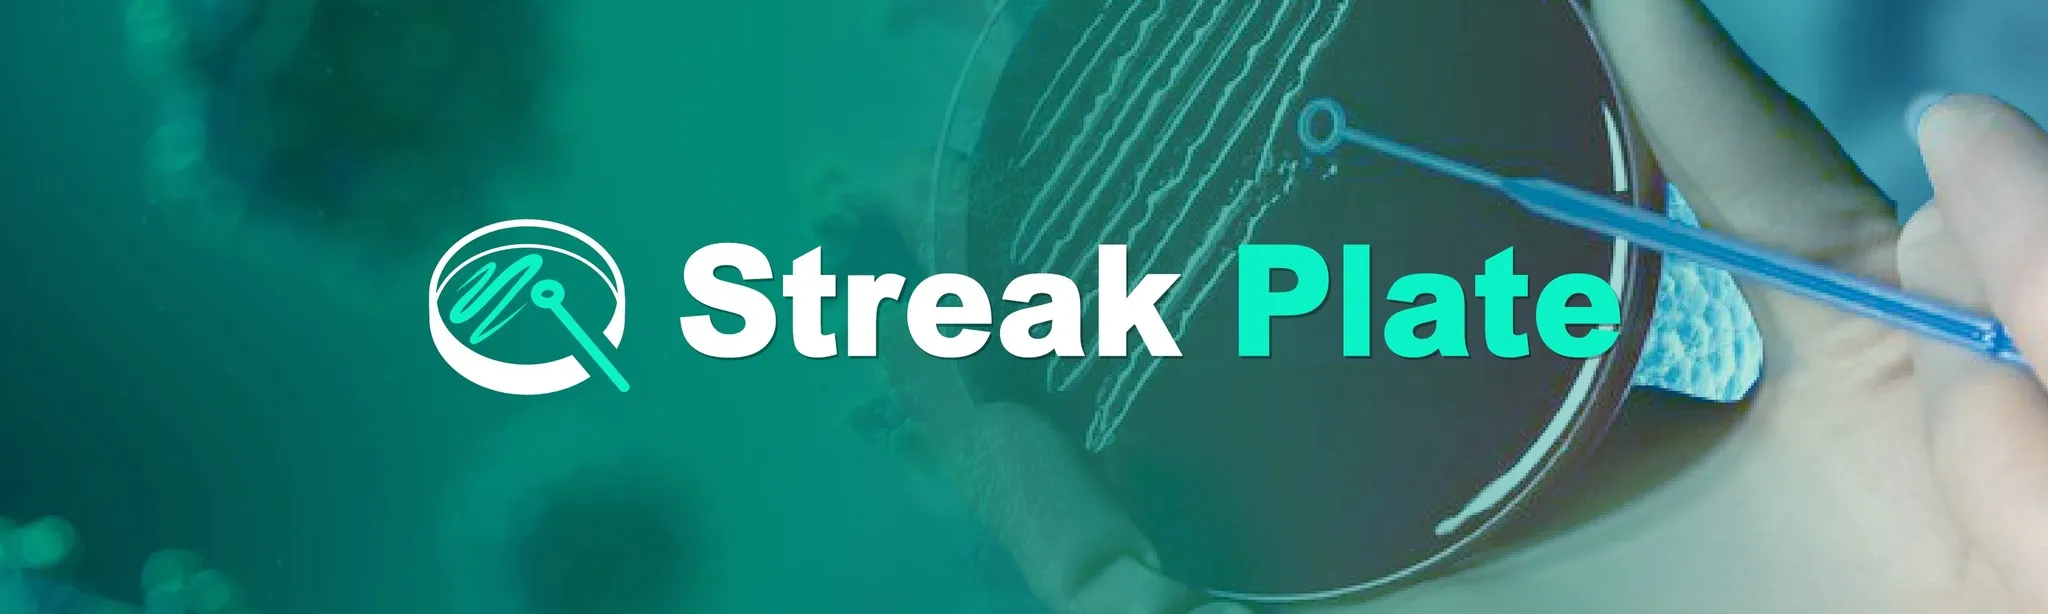

All VR Games published by Shangwei Digital Technology Co., Ltd.
Shangwei Digital Technology Co., Ltd. has published 3 games on the Meta Quest platform, accumulating 0 total ratings from players. with most titles receiving not enough reviews reviews from the community.
Filters
Include Tags
Exclude Tags
Price
Rating Score
Rating Count
Reality Type
Cross-Buy
Game Modes
Player Modes
Platform
Language
Age Rating
Comfort Level
Items per page:
 1. Gram stain Learning June 25, 2025 Not Enough Reviews $29.99 |
2. Streak Plate Learning June 29, 2025 Not Enough Reviews $29.99 |
 3. Season on Earth Simulation July 27, 2021 Not Enough Reviews $9.99 |